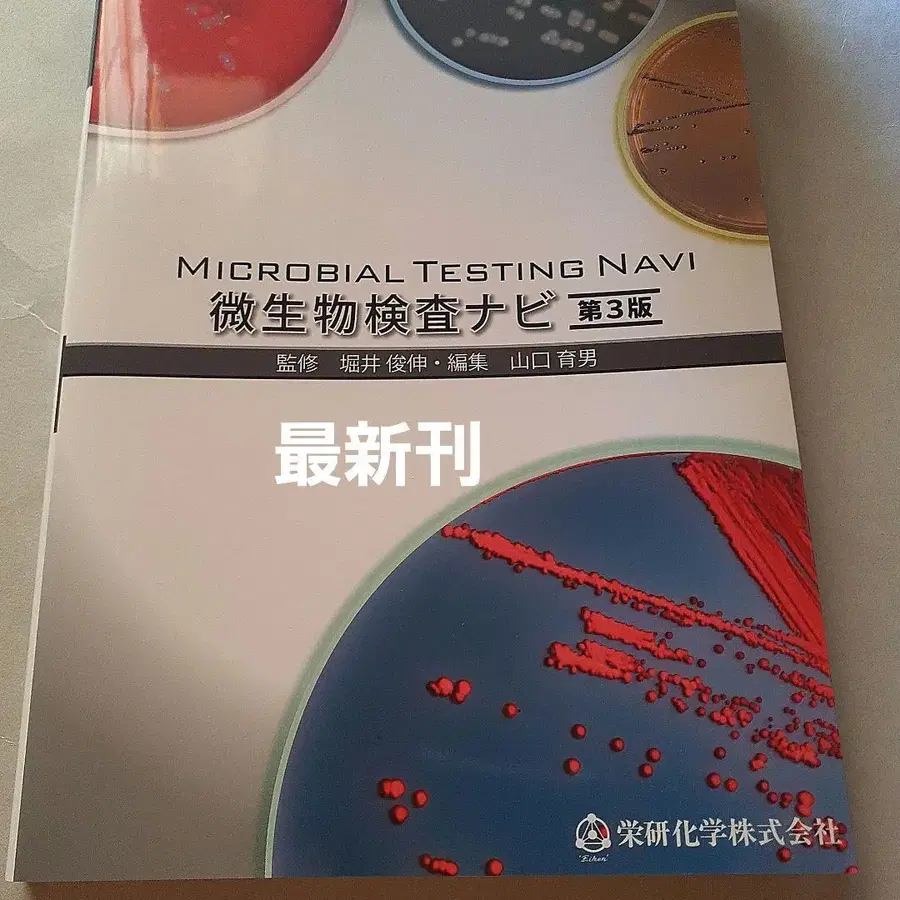

1 / 2
일본에서 배송되는 상품이에요
미생물 검사 내비 제3판 / 에이켄카가쿠
53,840원
해외 배송비,관부가세가 모두 포함된 가격지역정보 없음・6시간 전
0
메루카리(mercari)
일본 현지 세컨핸드를 국내 상품처럼 간편하게 구매4.8・거래후기 10,664・만족도 95%
4.8・거래후기 10,664・만족도 95%
결제혜택
번개장터 삼성카드 최대 20만 혜택토스페이 결제 시 번개포인트 최대 0.5% 적립더보기
퀵계좌이체 결제 시 0.3% 즉시 할인
컬쳐캐쉬 결제 시 최대 5천원 페이백
현대카드 최대 24개월 장기할부 혜택 제공
롯데카드 최대 24개월 장기할부 혜택 제공
하나카드 최대 18개월 장기할부 혜택 제공
국민카드 12개월 장기할부 혜택 제공
계좌 간편결제 시 번개포인트 1% 적립
무이자할부/카드포인트 결제 혜택 제공
카테고리
도서/티켓/문구〉도서〉기타(도서)
상품상태사용감 없음
수량1
- •본 상품은 메루카리 개인 판매자 상품으로, 번개장터의 파트너사가 상품 구매와 배송을 대행해요.
- •파트너사가 상품 구매 절차를 진행한 이후에는 취소/환불이 제한될 수 있어요. (단, 판매자가 동의하면 취소/환불 가능해요.)
- •통관 진행을 위해 수령인의 개인통관고유부호 입력이 필요해요.


![신약 성경 번역과 주석 제1권 (마르코 복음서/마태 복음서)]](https://media.bunjang.co.kr/product/357675038_1_1760787852_w360.jpg?crop=0)







![쿠레쿠레 타코라 스트랩 1997년제 [ BANDAI ]](https://media.bunjang.co.kr/product/363117406_1_1760624548_w360.jpg?crop=0)





![[레어] 하로키티 행운의 물건 시리즈 개운초복 필승운 2003](https://media.bunjang.co.kr/product/364609634_1_1761224944_w360.jpg?crop=0)








![[ 초판 오비 포함 ] 란마 1/2 메모리얼 북 다카하시 루미코](https://media.bunjang.co.kr/product/364639104_1_1761233925_w360.jpg?crop=0)


![[ 미개봉 새상품 ] 기계 공학 편람 DVD ROM 버전](https://media.bunjang.co.kr/product/364637103_1_1761233092_w360.jpg?crop=0)
![(새상품급) 학켄의 도감 근육맨 [초인] 최초 한정 케이스판](https://media.bunjang.co.kr/product/364635078_1_1761232265_w360.jpg?crop=0)







![치하야후루 카루타 [치하야후루] 공식 백인일수 카루타](https://media.bunjang.co.kr/product/364628956_1_1761230194_w360.jpg?crop=0)






![[ 최저가 ] 밑반찬 요리 레시피 도서 6권 세트](https://media.bunjang.co.kr/product/364616283_1_1761226629_w360.jpg?crop=0)




![사쿠라이 쇼의 건축을 둘러싼 여행. [ 현대 건축편 ]](https://media.bunjang.co.kr/product/364610244_1_1761225107_w360.jpg?crop=0)



